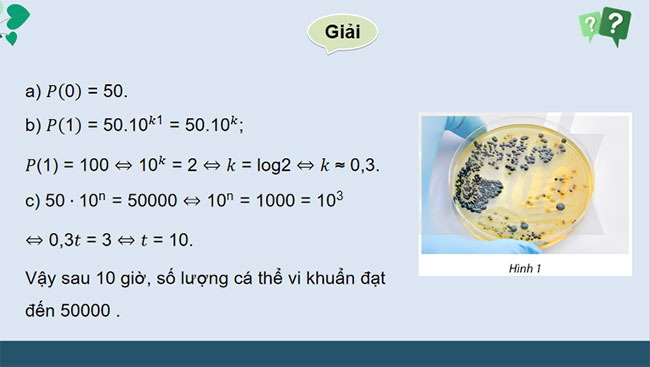

PowerPoint Toán 11 Bài tập cuối chương 6
Mua tài khoản Hoatieu Pro để trải nghiệm website Hoatieu.vn KHÔNG quảng cáo & Tải nhanh File chỉ từ 99.000đ. Tìm hiểu thêm »
Giáo án PowerPoint Toán 11 Bài tập cuối chương 6 được thiết kế hiện đại, tích hợp hình ảnh, hiệu ứng trình chiếu đẹp mắt với nhiều bài tập ôn tập, mở rộng kiến thức phong phú.
Giáo án Toán 11 Bài tập cuối chương 6 được biên soạn dưới dạng file PPT bám sát nội dung trong sách giáo khoa Chân trời sáng tạo Chương Hàm số mũ và hàm số lôgarit. Qua đó giúp giáo viên dễ dàng chỉnh sửa để có bài giảng hay, lôi cuốn người học. Vậy sau đây là trọn bộ giáo án PowerPoint Toán 11 Chân trời sáng tạo Bài tập cuối chương 6 mời các bạn tải tại đây.
Giáo án PowerPoint Toán 11 Bài tập cuối chương 6

.........
Mời các bạn tải file về để xem đầy đủ nội dung giáo án
-
Chia sẻ:
Trịnh Thị Thanh
- Ngày:
PowerPoint Toán 11 Bài tập cuối chương 6
9,2 MB 06/07/2025 4:58:00 CHNhiều người quan tâm
Tham khảo thêm
Theo Nghị định 147/2024/ND-CP, bạn cần xác thực tài khoản trước khi sử dụng tính năng này. Chúng tôi sẽ gửi mã xác thực qua SMS hoặc Zalo tới số điện thoại mà bạn nhập dưới đây:
- Chương 1: Hàm số lượng giác và phương trình lượng giác
- Chương 2: Dãy số. Cấp số cộng. Cấp số nhân
- Chương 3: Giới hạn. Hàm số liên tục
- Chương 4: Đường thẳng và mặt phẳng. Quan hệ song song trong không gian
- Chương 5: Các số đặc trưng đo xu thế trung tâm cho mẫu số liệu ghép nhóm
- Hoạt động thực hành và trải nghiệm
- Chương 6: Hàm số mũ và hàm số lôgarit
- Chương 7: Đạo hàm
- Chương 8: Quan hệ vuông góc trong không gian
- Chương 9: Xác suất
- Hoạt động thực hành và trải nghiệm
Giáo án lớp 11 tải nhiều
-
PowerPoint Tiếng Anh 11 Unit 2: Looking Back
-
PowerPoint Tiếng Anh 11 Unit 2: Getting Started
-
PowerPoint Tiếng Anh 11 Unit 2: Communication and Culture
-
PowerPoint Tiếng Anh 11 Unit 2: Reading
-
PowerPoint Tiếng Anh 11 Unit 2: Speaking
-
PowerPoint Tiếng Anh 11 Unit 2: Listening
-
PowerPoint Tiếng Anh 11 Unit 2: Language
-
PowerPoint Tiếng Anh 11 Unit 2: Writing
-
PowerPoint Tiếng Anh 11 Unit 1: Writing
-
PowerPoint Tiếng Anh 11 Unit 1: Language
Bài viết hay Giáo án lớp 11
-
PowerPoint Ngữ Văn 11 Bài 4: Thực hành tiếng Việt
-
PowerPoint Vật lí 11 Bài 6: Các đặc trưng vật lí của sóng
-
PowerPoint Tiếng Anh 11 Unit 10: Listening
-
PowerPoint Lịch sử 11 Bài 1: Một số vấn đề chung về cách mạng tư sản
-
Giáo án Sinh hoạt lớp 11 Cánh diều (Cả năm)
-
PowerPoint Địa lí 11 Bài 29: Thực hành tìm hiểu về kinh tế của Ô-xtrây-li-a